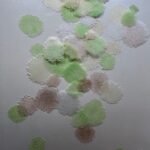
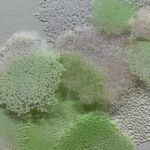

A collection of fine exhibitions makes the South Bay dazzle with their first 2024 exhibitions. So swing on down just below LAX and take in 6 terrific art events in three different spaces.
At the Torrance Art Museum, two perfectly realized exhibitions offer fresh, vibrant art. In Gallery One, don’t miss the group exhibition Western Values an exciting take on the mythos of the old west from cowboy tropes to historical implications.
Each piece is frankly outstanding, reinventing the powerful tales of Western fortitude and cultural heft in thoughtful works that vibrate with color. Outstanding video art from Julie Orser shapes a feminist version of gunslinger lore, with overlapping images on three giant screens. Shot in the Joshua Tree area, it’s cinematically stunning, and sharply pointed.
Curated by Sue-Na-Gay and Max Presneill, this is an exciting cultural reinvention and an artistic gem.
Exhibiting artists include Cara Romero, Dana Claxton, Edie Winograde, Ishi Glinsky, Julie Orser, Kyla Hansen, Manuello Paganelli, Pascual Sisto, River Garza, Rosson Crow.
Kyla Hansen’s neon-ribboned “Psychic” and Rosson Crow’s spray paint, oil, and acrylic rhapsody in reds, “Proud to be an American” are among the standouts.
In Gallery 2, the solo exhibition also resonates. “Everything You Say Can and Will Be Used Against You” from artist Brian Singer, uses a variety of sculptural objects to explore and expose our country’s responses to refugees, gentrification, surveillance, and other issues. Singer’s mother was interned during WWII, making both the beauty and the harsh truths behind these artworks as personal as they are potent.
Both exhibitions run through March 2nd. Torrance Art Museum is located at 3320 Civic Center Drive in Torrance, CA 90503
———————————————————————————————————————————————————-
In San Pedro, Angels Gate Cultural Center also has two exhibits, both group shows at this venue. 7 Visions X 7 Artists (above) features new and expansive creative works shaped under the auspices of the MRH Fund for Artists grant. This program follows Southern California artists on a year-long journey expanding their professional artist practice. Well curated by Georgia Freedman-Harvey, works include installations, sculptures, wall art by artists Cesar Garcia, Trinh Mai, Rebekah Mei, Nguyen Ly, Jas Parker, Edwin Vasquez, Patricia Yossen. You can read more about Vasquez’s work here.
The exhibition ran through February 24th.
Upstairs, phenomenal works using print making and found objects fill the larger gallery, with the stellar Printmaking with Recycled Materials, a group exhibition by LYNK Collective, curated by Christina Yasmin Fesmire and Jared Millar. Dramatic works utilize everything from fabric to melted plastic; it is a wonderfully dimensional and involving printmaking exhibitions that will exceed your ideas of what print making reveals. Artists include Yeansoo Aum, Elisabeth Beck, Andra Broekelschen, Alexandra Chiara, Christina Yasmin Fesmire, Karen Fiorito, Carole Gelker, Bill Jaros, Nguyen Ly, Diane McLeod, Jared Millar, William Myers, Marina Polic, Francisco Rogido, Olga Ryabtsova, Laura Shapiro, Tracy Loreque Skinner, Mary Lawrence Test, Paula Voss, Zana Zupur and guest artists: Karen Feuer-Schwager, Kim Kei, Wendy Murray, Jackie Nach, MJ Rado, Victor Rosas, Fred Rose, Marianne Sadowski, Jillian Thompson and Katie Thompson-Peer. Ly’s work is particularly mesmerizing.
There will be a closing event and talk on March 23rd from 2-4. Angels Gate is located at3601 S Gaffey St, San Pedro, CA 90731.
———————————————————————————————————————————————————-
And, at the Palos Verdes Art Center, glass and jewelry are the sparkling stars of a solo show featuring the jewelry – both wearable and highly fantastical from Ann Olsen Daub in Multifacted, and a mind-altering group of glass artists exhibiting in The Optics of Now: SoCal Glass.
In the group show, the artists create works that defy traditiona expectations of glass art, creating unique and fascinating works from a column of linked glass “paper clip” chains to neon infused fabric daisies. Seashells, sea foam, stained glass, and figurative works all dazzle as do the art deco stylings of Nao Yamamoto.
Among the standouts are otherworldly sculptures featuring crystals and ceramic from Nicole Stahl, and Danielle Brensinger‘s flamedworked glass “Column.” Exhibiting are: Paul Brayton, Danielle Brensinger, Adam Gregory Cohen, Mariah Armstrong Conner, Alexander Dixon, Stephen Dee Edwards, Katherine Gray, Michael Hernandez, Eric Huebsch, John Gilbert Luebtow, Gregory Price, Sara Roller, Nicole Stahl, Amanda McDonald Stern, Ethan Stern, Susan Stinsmuehlen-Amend, Hiromi Takizawa, Kazuki Takizawa, Deshon Tyau, and Nao Yamamoto.
Daub’s work is as whimsical as it is gorgeous. Giant gemstones, disco galls wearing crowns, a ring big enough for an elephant’s wedding, and examples of the artist’s wearble jewelry are all on display. All that glitters is gold here – or silver, mirror, and glass.
Palos Verdes Art Center is located at 5504 Crestridge Rd, Rancho Palos Verdes, CA 90275 Both shows are on view through April 13th.
- Genie Davis; photos by Genie Davis